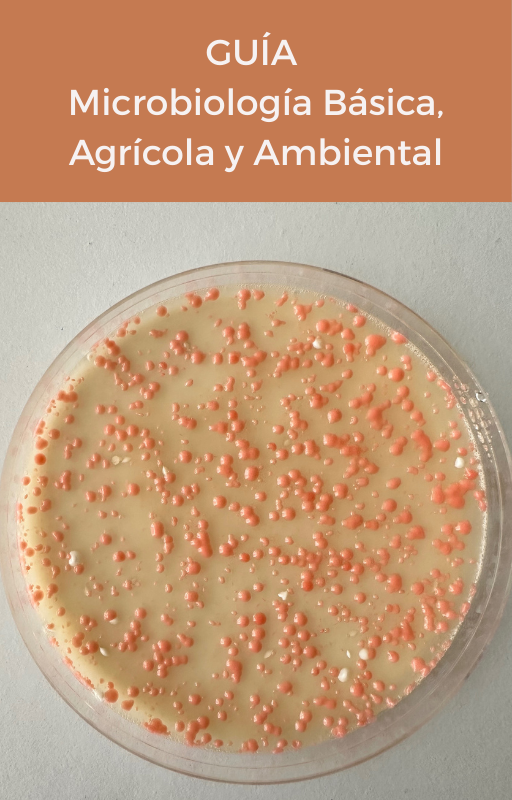

Guía - Microbiología Básica, Agrícola y Ambiental
Lillian Frioni es profesora de Microbiología de la Facultad de Agronomía de la Universidad de la República, de Montevideo, Uruguay, responsable de la Unidad Asociada Ecología Microbiana de la Facultad de Ciencias, de la misma Universidad, e investigadora del PEDECIBA (Programa de Desarrollo de Ciencias Básicas).
Trabajó por más de diez años en la Facultad de Agronomía y Veterinaria de la Universidad Nacional de Río Cuarto y en la de Rosario (Santa Fe) y colaboró también con la Facultad de Ciencias Agronómicas de la Universidad Nacional de Córdoba, en Argentina.
Integró en numerosas oportunidades la Comisión Directiva de la Sociedad Uruguaya de Microbiología (SUM).
Realizó estudios en la Universidad de la República (Uruguay), en la Universidad d ́Orsay y en el Instituto Pasteur (Paris), en el Centro de Pedología Biológica de Nancy (Francia), y en el Laboratorio de Sistemas Simbióticos Fijadores de Nitrógeno Tropicales de Nogent sur Marne, Francia.
Microbiología, Básica, ambiental y agrícola es su tercer texto. El primero Ecología microbiana del suelo, fue editado en 1990 por la Universidad de la República, de Uruguay, luego de obtener un premio de la Colección Reencuentro. El segundo, Procesos microbianos, fue editado en 1999 por la Fundación de la Universidad Nacional de Río Cuarto (Argentina).
ISBN: 9974-0-0290-7